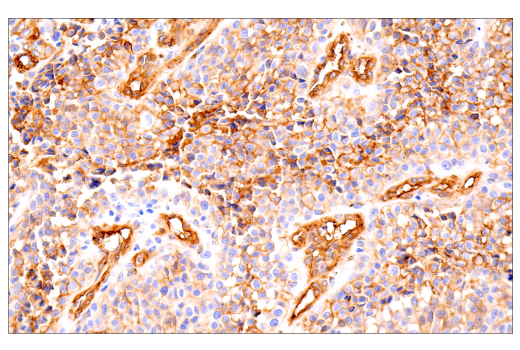
undefined Image 38: Pericyte Antibody Sampler Kit

Revision 1
#76879
Store at -20C
Pericyte Antibody Sampler Kit
1 Kit
(8 x 20 microliters)
877-616-CELL (2355)
877-678-TECH (8324)
3 Trask Lane | Danvers | Massachusetts | 01923 | USA
For Research Use Only. Not for Use in Diagnostic Procedures.
| Product Includes | Product # | Quantity | Mol. Wt | Isotype/Source |
|---|---|---|---|---|
| PDGF Receptor beta (28E1) Rabbit Monoclonal Antibody | 3169 | 20 µl | 190 kDa | Rabbit IgG |
| alpha-Smooth Muscle Actin (D4K9N) Rabbit Monoclonal Antibody | 19245 | 20 µl | 42 kDa | Rabbit IgG |
| Desmin (D93F5) Rabbit Monoclonal Antibody | 5332 | 20 µl | 53 kDa | Rabbit IgG |
| MCAM (E3F3E) Rabbit Monoclonal Antibody | 81701 | 20 µl | 120 kDa | Rabbit IgG |
| CD13/APN (D6V1W) Rabbit Monoclonal Antibody | 32720 | 20 µl | 160 kDa | Rabbit IgG |
| CD31 (PECAM-1) (D8V9E) Rabbit Monoclonal Antibody | 77699 | 20 µl | 135 kDa | Rabbit IgG |
| CD31 (PECAM-1) (89C2) Mouse Monoclonal Antibody | 3528 | 20 µl | 130 kDa | Mouse IgG1 |
| NG2/CSPG4 (E3B3G) Rabbit Monoclonal Antibody | 43916 | 20 µl | 250, 450 kDa | Rabbit IgG |
| Anti-rabbit IgG, HRP-linked Antibody | 7074 | 100 µl | Goat | |
| Anti-mouse IgG, HRP-linked Antibody | 7076 | 100 µl | Horse |
Please visit cellsignal.com for individual component applications, species cross-reactivity, dilutions, protocols, and additional product information.
Description
Storage
Background
The cytoskeleton consists of three types of cytosolic fibers: microfilaments (actin filaments), intermediate filaments, and microtubules. Actin proteins are major components of the eukaryotic cytoskeleton. At least six vertebrate actin isoforms have been identified. The cytoplasmic β- and γ-actin proteins are referred to as “non-muscle” actin proteins as they are predominantly expressed in non-muscle cells where they control cell structure and motility (3). The α-cardiac and α-skeletal actin proteins are expressed in striated cardiac and skeletal muscles, respectively. The smooth muscle α-actin and γ-actin proteins are found primarily in vascular smooth muscle and enteric smooth muscle, respectively. The α-smooth muscle actin (ACTA2) is also known as aortic smooth muscle actin. These actin isoforms regulate the contractile potential of muscle cells (4).
The intermediate filament desmin is a myogenic marker expressed in early development that forms a network of filaments extending across the myofibril and surrounding Z discs. The desmin cytoskeleton provides a connection among myofibrils, organelles, and the cytoskeleton (5). Melanoma cell adhesion molecule (MCAM, MUC18, CD146) is a marker protein seen in vascular endothelial cells, activated T lymphocytes, smooth muscle, and bone marrow stromal cells. Endothelial MCAM within the BBB acts as adhesion receptors that permit lymphocytes to transmigrate across the barrier and produce inflammatory lesions (6). MCAM also functions as a co-receptor for PDGFR-β on pericytes to regulate pericyte-EC interactions (7).
CD31 (Platelet Endothelial Cell Adhesion Molecule-1: PECAM-1), a member of the Ig superfamily of cell adhesion molecules, is expressed by circulating platelets, monocytes, neutrophils, some T cells, and endothelial cells and modulates cell adhesion, endothelial cell migration, and angiogenesis. CD31 serves as a scaffold for various signaling molecules and is a possible gate-keeper receptor in the inflammatory blood–brain axis (8).
Aminopeptidase N (APN, CD13) is a metalloprotease expressed on myeloid cells, pericytes, fibroblasts, epithelial and endothelial cells, as well as on tumor cells, and stem cells. APN/CD13 acts as an adhesion molecule that modulates inflammatory immune cell trafficking, resulting in injury progression (9).
The chondroitin sulfate proteoglycan NG2 is a type I membrane protein expressed by subpopulations of glia, including oligodendroglial precursor cells and a variety of tumor cells (10). Although NG2 is not expressed in adult central nervous system (CNS) pericytes, it is an early marker of pericyte activation during CNS development and pathological conditions. Thus, upon CNS injury, NG2-reactive pericytes are found along microvessels, where they act as sensors for inflammation and support the immunosurveillance and effector function of extravasated neutrophils and macrophages (11).
Background References
- Kadry, H. et al. (2020) Fluids Barriers CNS 17, 69.
- Wu, D. et al. (2023) Signal Transduct Target Ther 8, 217.
- Herman, I.M. (1993) Curr Opin Cell Biol 5, 48-55.
- Eng, L.F. et al. (2000) Neurochem Res 25, 1439-51.
- Capetanaki, Y. et al. (2007) Exp Cell Res 313, 2063-76.
- Duan, H. et al. (2013) Sci Rep 3, 1687.
- Newman, P.J. (1997) J Clin Invest 99, 3-8.
- Zhang, Z. et al. (2023) J Cereb Blood Flow Metab 43, 1027-1041.
- Nguyen, J.N. et al. (2023) J Neuroinflammation 20, 232.
- Karram, K. et al. (2005) J Anat 207, 735-44.
- Ferrara, G. et al. (2016) Acta Neuropathol 132, 23-42.
Trademarks and Patents
Cell Signaling Technology is a trademark of Cell Signaling Technology, Inc.
All other trademarks are the property of their respective owners. Visit cellsignal.com/trademarks for more information.
Limited Uses
Except as otherwise expressly agreed in a writing signed by a legally authorized representative of CST, the following terms apply to Products provided by CST, its affiliates or its distributors. Any Customer's terms and conditions that are in addition to, or different from, those contained herein, unless separately accepted in writing by a legally authorized representative of CST, are rejected and are of no force or effect.
Products are labeled with For Research Use Only or a similar labeling statement and have not been approved, cleared, or licensed by the FDA or other regulatory foreign or domestic entity, for any purpose. Customer shall not use any Product for any diagnostic or therapeutic purpose, or otherwise in any manner that conflicts with its labeling statement. Products sold or licensed by CST are provided for Customer as the end-user and solely for research and development uses. Any use of Product for diagnostic, prophylactic or therapeutic purposes, or any purchase of Product for resale (alone or as a component) or other commercial purpose, requires a separate license from CST. Customer shall (a) not sell, license, loan, donate or otherwise transfer or make available any Product to any third party, whether alone or in combination with other materials, or use the Products to manufacture any commercial products, (b) not copy, modify, reverse engineer, decompile, disassemble or otherwise attempt to discover the underlying structure or technology of the Products, or use the Products for the purpose of developing any products or services that would compete with CST products or services, (c) not alter or remove from the Products any trademarks, trade names, logos, patent or copyright notices or markings, (d) use the Products solely in accordance with CST Product Terms of Sale and any applicable documentation, and (e) comply with any license, terms of service or similar agreement with respect to any third party products or services used by Customer in connection with the Products.
Revision 1



Revision 1



Revision 1



Revision 1



Revision 1



Revision 1



Revision 1



Revision 1



Revision 1



Revision 1



Revision 1



Revision 1



Revision 1

Revision 1



Revision 1



Revision 1



Revision 1



Revision 1



Revision 1



Revision 1



Revision 1



Revision 1



Revision 1



Revision 1



Revision 1


Immunohistochemical analysis of paraffin-embedded rat brain using alpha-Smooth Muscle Actin (D4K9N) XP® Rabbit mAb.

Revision 1



Revision 1



Revision 1



Revision 1



Revision 1



Revision 1
